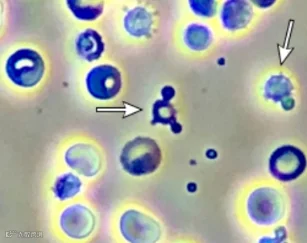

尿常规报告见潜血(+),是不是得了肾炎?
别慌,让医生来分析。

镜下血尿

正常的尿液中没有或仅有少量红细胞,离心尿液在显微镜高倍视野(HP)下偶然发现 1~2 个红细胞属正常现象;若红细胞>3个/HP则称为血尿。
红细胞量少时,仅能靠显微镜检查做出诊断,称镜下血尿(即尿潜血)。
若每升尿液中有>1 ml血液时即肉眼即可看到尿液呈血样或呈洗肉水样,称为肉眼血尿。

常见病因

血尿可以由泌尿系统疾病引起(占绝大多数,比如泌尿系结石、肿瘤、结核、感染、外伤;肾小球肾炎、肾间质疾病、肾血管疾病),也可能是由全身性疾病或泌尿系统邻近器官病变所致。

诊断思路

体检发现尿潜血阳性,是肾病门诊遇到遇到的情形。患者多数没有症状,仅在体检时或在其它疾病的诊治过程中偶然发现。
对于血尿的病因,医生和患者一样非常重视,因此需要展开必要的检查。
Q
STEP 1
首先,要详细询问病史(重点:高血压病、肝病、感染、过敏、接触物、药物等等)、家族史(遗传性肾炎、多囊肾病),了解有无相关疾病的危险因素。

Q
STEP 2
其次,重复检测2-3次。鉴别是偶然性还是病理性的异常。经期女性、剧烈运动后、急性创伤后采集的尿液存在潜血,有可能是正常的。
同时,检查尿红细胞位相(尿红细胞形态)。鉴别是肾小球性血尿还是非肾小球性血尿。一般认为,尿红细胞异形率>80% 时考虑为肾小球源性血尿,<50%时考虑为非肾小球源性血尿。

尿红细胞呈正常形态(双凹圆盘状,大小均一),
提示非肾小球来源。
尿红细胞呈畸形(形态、大小不一),出现棘形红细胞,提示肾小球疾病。
Q
STEP 3
根据尿红细胞来源的不同展开进一步的检查。
A
寻找其它肾损伤的证据:血肌酐、尿素氮、胱抑素C升高?尿红细胞管型、尿白细胞管型?新发高血压或原有高血压加重?新发水肿或原有水肿加重?
是否存在上呼吸道疾病的症状或近期上呼吸道感染?
是否伴有蛋白尿?→尿蛋白定量、尿蛋白分类
瘦长体型?→左肾静脉彩超
符合肾炎综合征(血尿+蛋白尿+血压升高)?→鉴别原发性、继发性肾小球肾炎(各种免疫学检查)→判断肾活检指征

B
对于非肾小球性血尿,且凝血功能正常,根据其它临床特点展开相应的检查。
尿路刺激征(尿频尿急尿痛)→尿细菌培养、找抗酸杆菌、泌尿系彩超
结石病史、肾绞痛→泌尿系彩超、腹部平片、肾盂造影
特殊用药史(环磷酰胺、大剂量止痛药、马兜铃酸)、化学物品接触史(芳香胺、苯系物)、盆腔放疗史、前列腺增生病史→CT、膀胱镜
总结如图:


严重吗?

不能一概而论。
肾小球疾病表现为单纯镜下血尿,而不合并蛋白尿及肾功能异常,通常不需要肾穿刺活检,建议每半年至 1 年复查尿常规,并进行健康的生活方式调整。
对于非肾小球源性血尿,通过影像学检查(B超/CT/MR等)明确具体病因并进行对应的治疗或管理。
对于经过详细检查仍未能明确病因的情况,可以随访2年。若结果阴性,可结束随访。若镜下血尿仍持续存在超过3年,应重新评估。
专家简介
吴禹池
广东省中医院肾病科副主任医师
医学博士
师从广东省名中医黄春林教授,张琪学术经验传承工作室骨干成员,广东省中医院朝阳人才,岭南肾病流派学术传承人,广东省中西医结合学会肾病专业委员会委员兼秘书。
▇ 擅长
以中医药为主、中西医结合治疗肾炎、肾病综合征、肾功能衰竭、糖尿病肾病、高血压肾病等肾脏疾病以及尿路感染、尿路结石、前列腺炎、男性功能障碍等。
▇ 出诊时间

康合上医门诊
(广东省中医院协作医院)
(广东省中医院慢病管理平台)
周五下午14:30-17:30

广东省中医院大德路总院
研修楼慢病管理-肾病专科
周五上午8:00-11:30
(本文转载自公众号“肾科大夫吴禹池”)





